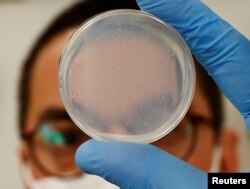
Chief Technical Officer Hirotsu Bio Science Eric Di Luccio berpose dengan nematoda dalam cawan petri di lab perusahaan di Fujisawa, Prefektur Kanagawa, Jepang 28 November 2022. REUTERS/Kim Kyung-Hoon

Hirotsu Bio Science bulan ini meluncurkan perangkat tes kanker pankreas N-Nose plus, yang dipasarkan langsung ke konsumen di Jepang. Targetnya adalah membawa tes itu ke pasar AS pada tahun 2023.
Pengguna mengirimkan sampel urinenya melalui kantong surat khusus ke laboratorium, di mana sampel itu ditaruh di cawan petri bersama dengan satu spesies nematoda atau cacing. Makhluk tersebut, yang secara ilmiah dikenal sebagai C. elegans, memiliki indra penciuman yang jauh lebih kuat daripada penciuman anjing, kata perusahaan tersebut. Menurut perusahaan itu, penciuman cacing itu mengarah ke sel-sel kanker.
Ini membuat hewan sepanjang 1 milimeter tersebut menjadi perangkat diagnostik yang ampuh, kata pendiri dan CEO Hirotsu Bio Science, Takaaki Hirotsu, yang telah meneliti cacing itu selama 28 tahun.
Hirotsu mengatakan, "Yang paling penting dengan deteksi dini kanker dan jenis-jenis penyakit ini adalah mampu merasakan jejak sekecil apapun. Dan terkait hal ini, saya pikir mesin tidak dapat melawan kemampuan yang dimiliki makhluk hidup itu.”
Hirotsu Bio meluncurkan tes konsumen N-NOSE-nya yang pertama pada Januari 2020. Tes itu mengklaim mampu memberitahu apakah pengguna memiliki risiko tinggi mengidap kanker itu atau tidak. Sekitar 250 ribu orang telah melakukan tes awal, dengan sekitar lima persen-enam persen didapati berisiko tinggi.
Dalam versi terbarunya, perusahaan itu mengubah kode genetik nematoda tersebut sehingga makhluk ini akan menjauh dari sampel kanker pankreas. Hirotsu Bio mengawali tesnya untuk kanker pankreas karena pendiagnosisannya yang sulit dan perkembangannya yang cepat.
Dalam beberapa tahun mendatang, perusahaan ini berharap dapat meluncurkan tes-tes yang ditargetkan untuk kanker hati, kanker leher rahim dan kanker payudara.
Perangkat tes pankreas ini harganya bisa mencapai 70 ribu yen (sekitar Rp7,98 juta), relatif mahal untuk tes diagnostik di Jepang, yang memiliki sistem layanan kesehatan nasional dan harga tetap untuk obat serta prosedur pengobatan.
Harga itu, selain iklan di televisi yang menggunakan karikatur mengenai cacing dan pankreas, merupakan bagian dari proses mengembangkan merek, kata Hirotsu, seraya menambahkan bahwa harga itu bisa turun seiring dengan peningkatan skala perusahaan.
Beberapa dokter telah mengkritik pendekatan semacam ini kepada konsumen dan meragukan kegunaan hasilnya untuk keperluan medis.
Masahiro Kami, kepala lembaga kajian Medical Governance Research Institute di Tokyo, mengatakan bahwa banyaknya hasil tes positif palsu dapat jauh melampaui kasus aktual kanker pankreas, sehingga membuat hasilnya “tidak dapat digunakan.”
Hirotsu Bio menanggapi dengan mengatakan akurasi N-NOSE tetap valid dibandingkan dengan tes-tes diagnostik lainnya dan dimaksudkan sebagai perangkat deteksi dini yang dapat memandu pasien untuk melakukan tes lebih jauh dan perawatan lebih cepat.
Hirotsu menambahkan,"Kanker pankreas hampir-hampir tidak dapat dideteksi pada tahap awal, dan tidak ada tes di dunia untuk mendeteksi tahap paling awal dari kanker pankreas. Tetapi sejak tahun lalu, kami telah mengukuhkan bahwa N-NOSE bereaksi terhadap tahap awal kanker pankreas. Karena itu kami dapat mengembangkan tes pertama di dunia untuk mendeteksi tahap awal kanker pankreas.” [uh/ab]

Forum